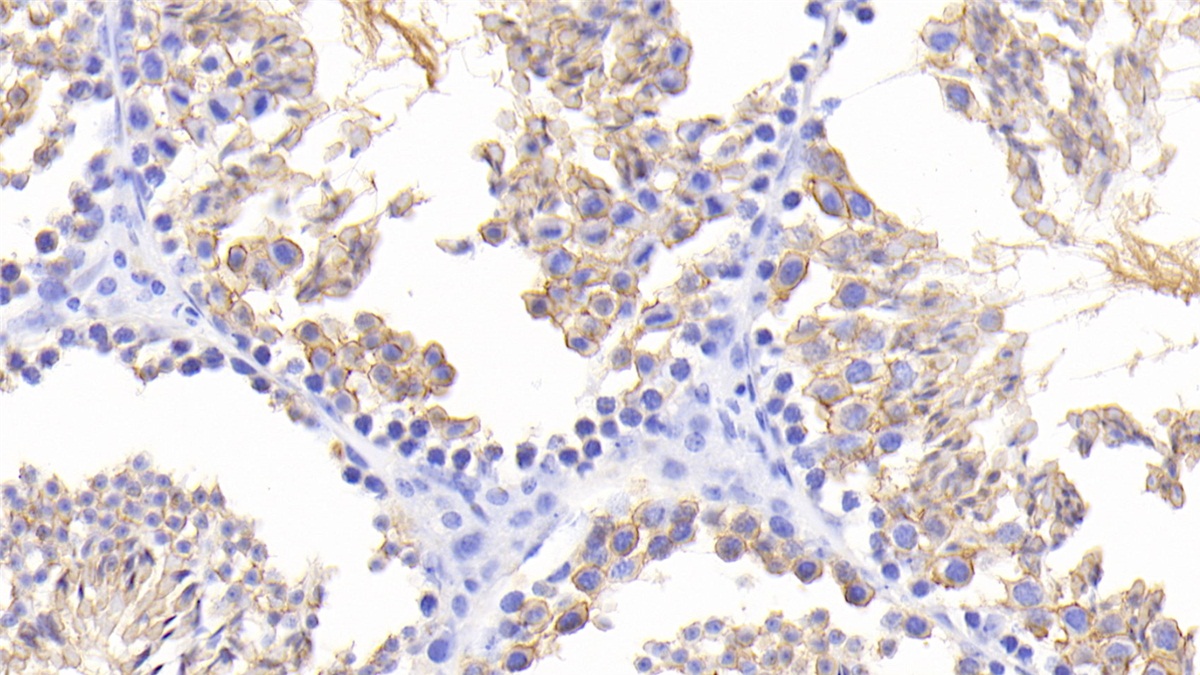
Growth Differentiation Factor 6 (GDF6) Mouse Polyclonal Antibody

| Pack Size | 100ul, 1ml, 200ul, 20ul |
|---|---|
| Applications | WB; IHC; ICC; IP. |
| Host Species | Rabbit |
| Antibody Type | Polyclonal Antibody |
| Organism Species | Mus musculus (Mouse) |
| Concentration | 500 ug/ml |
| Product Synonyms | Growth Differentiation Factor 6 (GDF6) |
| Alternative Names | BMP13; CDMP2; GDF16; Bone morphogenetic protein 13; Growth/differentiation factor 16 |
| Immunogen (Antigen) | Growth Differentiation Factor 6 |
| Buffer Formulation | 1mM DTT, 5% Trehalose and Proclin300., containing 0.01% SKL, PBS, pH7.4 |
| Uniprot ID | P43028 |
| Gene ID | 242316 |
| Purification | Antigen-specific affinity chromatography followed by Protein A affinity chromatography |
| Usage | For Research Use Only. Not for diagnostics or human use. |
| Shelf Life | 12 months at time of shipping |
| Shipping | Shipped in Dry Ice at -20 Degree Celsius |
| Storage | Store at -20 Degree Celsius. It is recommended to aliquot and store to avoid repeated freeze-thaw as it affects the stability of the antibody. |
| Research Areas | Bone Metabolism, Cancer, Cell Biology, Immunology |
| Disclaimer | The data indicated herein are as indicated and validated in our laboratory. These reagents are for research use only and not for in-vitro diagnostics or human use. |
Growth Differentiation Factor 6 (GDF6) Mouse Polyclonal Antibody
$20.00 – $210.00
SKU:KDXA117579
Categories:Polyclonal Antibodies
Be the first to review “Growth Differentiation Factor 6 (GDF6) Mouse Polyclonal Antibody” Cancel reply
Related Products
-
Sale
Select options This product has multiple variants. The options may be chosen on the product page Quick View Add to wishlist -
Sale
Select options This product has multiple variants. The options may be chosen on the product page Quick View Add to wishlist -
Sale
Select options This product has multiple variants. The options may be chosen on the product page Quick View Add to wishlist -
Sale
Select options This product has multiple variants. The options may be chosen on the product page Quick View Add to wishlist -
Sale
Select options This product has multiple variants. The options may be chosen on the product page Quick View Add to wishlist -
Sale
Select options This product has multiple variants. The options may be chosen on the product page Quick View Add to wishlist
Reviews
There are no reviews yet.